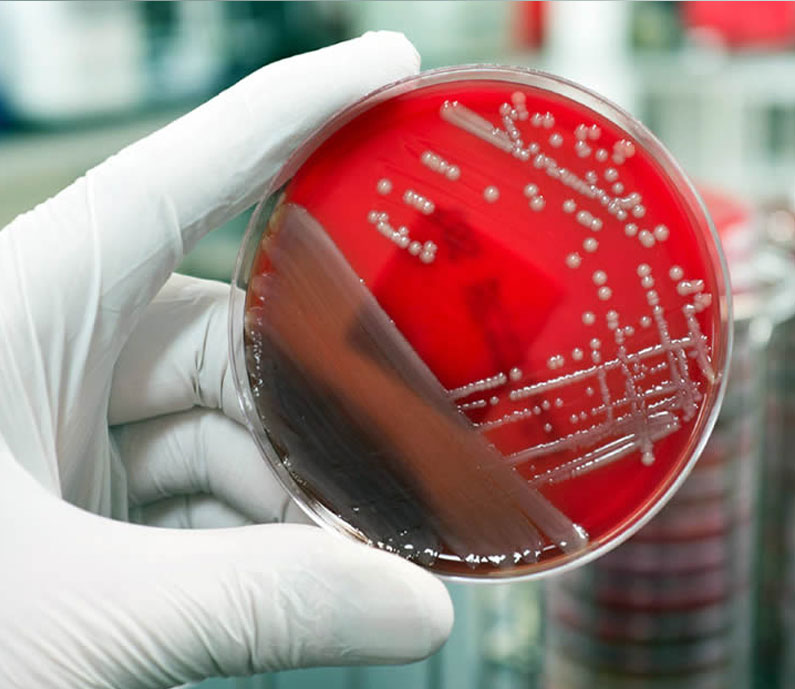
Estudio de vida util carcasa de pollo
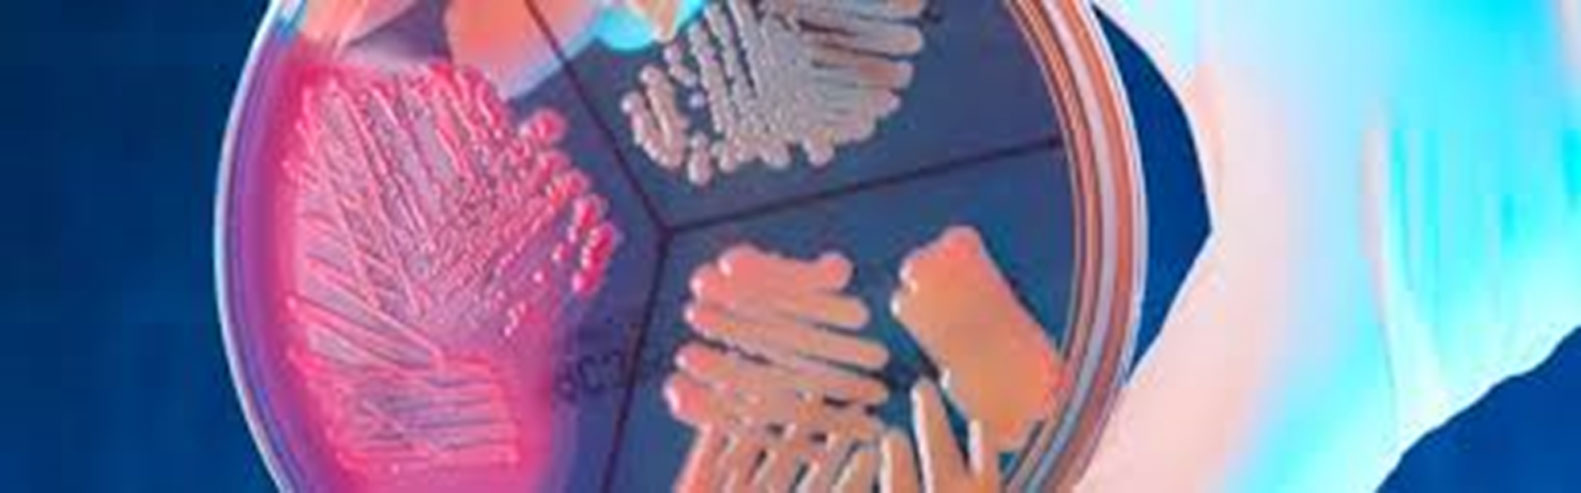
Microbiolgico ambientes

|
Microbiológico agua de piscinas |
• Recuento de microorganismos Mesofilos aerobios • Recuento de Coliformes totales • Recuento de microorganismos termotolerantes • Recuento de E. coli • Recuento de Pseudomona aeruginosa |
|
|
|
|
Microbiológico de agua potable |
• Recuento de microorganismos Mesofilos aerobios • Recuento de Coliformes totales • Recuento de E. coli • Recuento de Pseudomona aeruginosa |
|
|
|
|
Microbiológico alimentos |
• Recuento de Mesofilos aerobios • Recuento de E. coli • Recuento de Mohos y Levaduras • Recuento de Coliformes totales y fecales • NMP de Coliformes totales y fecales • Recuento de Staphylococcus aureus coagulasa positiva • Determinación de Salmonella spp. • Recuento de Pseudomona aeruginosa • Determinación de Vibrio Cholerae O1 • Recuento de esporas de Clostridium Sulfito Reductor • Determinación de Listeria monocytogenes |
|
|
|
|
Estudio de vida útil carcasa de pollo |
• Recuento de Mesofilos aerobios • Recuento de E. coli • Recuento de Coliformes totales • Recuento de Staphylococcus aureus coagulasa positiva • Recuento de Pseudomona aeruginosa • Determinación de Salmonella spp. • pH • Humedad
|
|
|
|
|
Valoración de desinfectantes |
• Concentración mínima inhibitoria (CMI) • Tiempo mínimo de contacto (TMC) |
|
|
|
|
Microbiológico de ambientes |
• Recuento de Mesofilos aerobios, • Recuento de Mohos y levaduras |
|
|
|
|
Microbiológico de Superficies |
• Recuento de Mesofilos aerobios • Recuento de Coliformes Totales • Recuento de Escherichia coli • Recuento de Mohos y Levaduras |
|
|
|
|
Microbiológico de Manipuladores |
• Recuento de Coliformes Totales • Recuento de Escherichia coli • Recuento de Staphylococcus aureus coagulasa positiva • Recuento de Mohos y Levaduras |